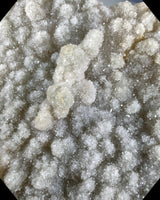

Green Amethyst Plate
Crave's Crystals
$300.00
A spectacular Green Amethyst plate of high quality with all the features and fit for any collection.
Stone: Green Amethyst
Type: Natural Cluster Plate
Locale: Brazil
Meta-Physical Properties: Green Amethyst helps to ease discomfort for those who find it difficult to express emotion. It is a reminder that all are part and parcel of the Divine, unconditional loving Source. Those who have issues of self worth or lack self-confidence will find working with Green Amethyst helps to foster a deep appreciation and acceptance of self.
Corresponding Astrological Signs: Scorpio
Size:
7.5 inches by 5.5 inches
1,064 grams / 2 pounds 5.5 ounces